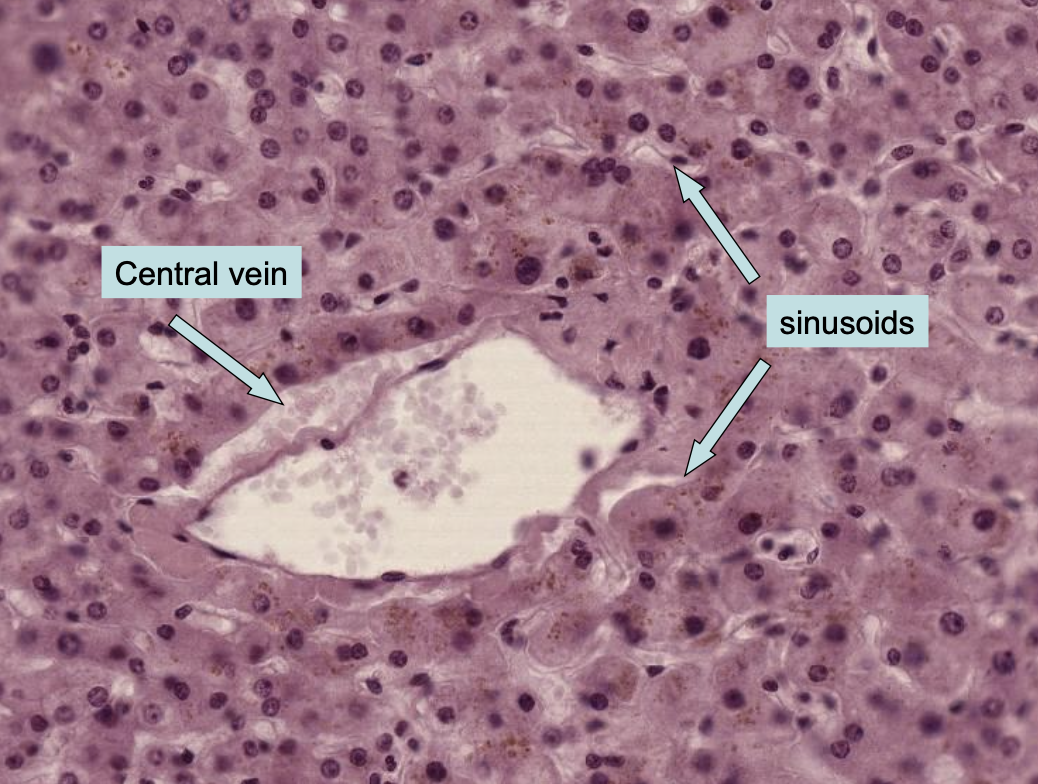

1
Q

A

2
Q

A

3
Q

A

4
Q

A

5
Q

A

6
Q

A

7
Q

A
GALL BLADDER

8
Q

A

9
Q

A

10
Q

A

11
Q

A

12
Q

A
a.) portal vein
b.) hepatic artery
c.) bile duct
d.) sinusoids
13
Q
What organ is this?

A
Liver human
14
Q
What organ is this?

A
Liver human
15
Q

A

16
Q

A

17
Q

A
liver

18
Q

A
liver
19
Q

A
reticular fibers of liver
20
Q

A
liver: kupffer cells

21
Q
What is this

A
gallbladder bile canaliculi
22
Q

A
gallbladder bile canaliculi
23
Q

A
gallbladder bile canaliculi
24
Q

A

25
what organ is this?

gallbladder
26

gallbladder

27

pancreatic acinar cell in an enzyme producing cell
28


29

islet of langerhans
30
what organ is this

pancreas
31


32


33

pancreas

34
What organ is this

pancreas
35


36




